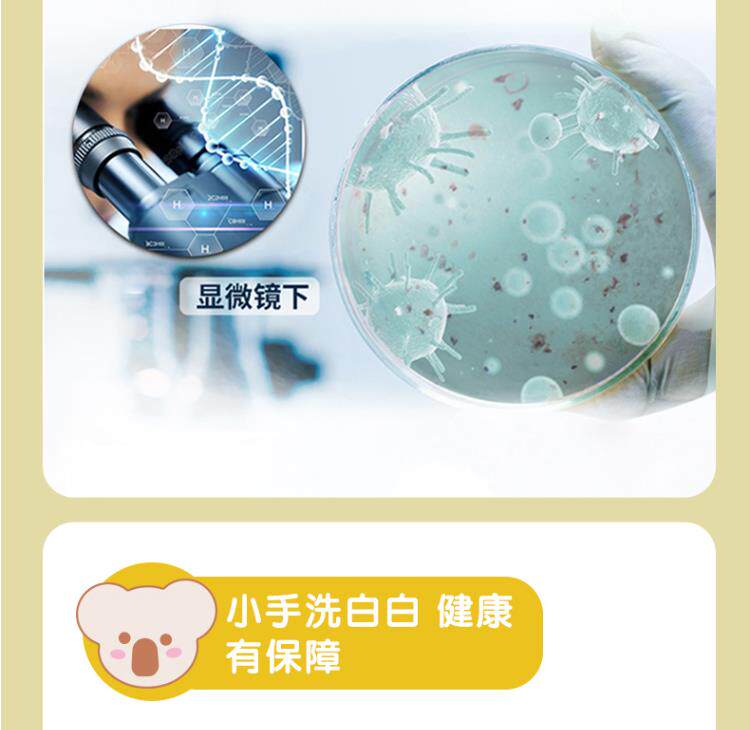

Детский антибактериальный санитайзер для рук, сменное детское средство детской гигиены для одевания для домашнего использования, 300 мл

Цена: 419руб. (¥19.8)
Артикул: 35501107218
Вес товара: ~0.7 кг. Указан усредненный вес, который может отличаться от фактического. Не включен в цену, оплачивается при получении.
Описание товараPHA+PGltZyBjbGFzcz0iZGVzY19hbmNob3IiIGlkPSJkZXNjLW1vZHVsZS0xIiBzcmM9Imh0dHBzOi8vYXNzZXRzLmFsaWNkbi5jb20va2lzc3kvMS4wLjAvYnVpbGQvaW1nbGF6eWxvYWQvc3BhY2ViYWxsLmdpZiI+PHA+0J7QsdC90L7QstC70LXQvdC40LUg0YPQv9Cw0LrQvtCy0LrQuCwg0LIg0L3QsNGB0YLQvtGP0YnQtdC1INCy0YDQtdC80Y8g0L3QvtCy0L7QtSDQuCDRgdGC0LDRgNC+0LUg0YHQvNC10YjQsNC90L3QvtC1LCDQvdCwINC+0YHQvdC+0LLQtSDRgNC10LDQu9GM0L3QvtCz0L4g0L7QsdGK0LXQutGC0LA8L3A+PHA+PGltZyBzcmM9Imh0dHBzOi8vaW1nLmFsaWNkbi5jb20vaW1nZXh0cmEvaTEvMTY2OTYzNDIxOS9PMUNOMDF4R01OV0ExaDJMYmtXRzA2Nl8hITE2Njk2MzQyMTkuanBnIiBhbGlnbj0iYWJzbWlkZGxlIj48aW1nIHNyYz0iaHR0cHM6Ly9pbWcuYWxpY2RuLmNvbS9pbWdleHRyYS9pMS8xNjY5NjM0MjE5L08xQ04wMXVZeEdXbzFoMkxicURnQ0oyXyEhMTY2OTYzNDIxOS5qcGciIGFsaWduPSJhYnNtaWRkbGUiPjxpbWcgc3JjPSJodHRwczovL2ltZy5hbGljZG4uY29tL2ltZ2V4dHJhL2kzLzE2Njk2MzQyMTkvTzFDTjAxcjUyQ3RZMWgyTGJ0NkRHWGVfISExNjY5NjM0MjE5LmpwZyIgYWxpZ249ImFic21pZGRsZSI+PGltZyBzcmM9Imh0dHBzOi8vaW1nLmFsaWNkbi5jb20vaW1nZXh0cmEvaTMvMTY2OTYzNDIxOS9PMUNOMDFnNWtMZXUxaDJMYnFkQXdyUV8hITE2Njk2MzQyMTkuanBnIiBhbGlnbj0iYWJzbWlkZGxlIj48aW1nIHNyYz0iaHR0cHM6Ly9pbWcuYWxpY2RuLmNvbS9pbWdleHRyYS9pMi8xNjY5NjM0MjE5L08xQ04wMXN2WHFCVTFoMkxicURmdmd2XyEhMTY2OTYzNDIxOS5qcGciIGFsaWduPSJhYnNtaWRkbGUiPjxpbWcgc3JjPSJodHRwczovL2ltZy5hbGljZG4uY29tL2ltZ2V4dHJhL2kyLzE2Njk2MzQyMTkvTzFDTjAxckY4NHB5MWgyTGJrV0gwU3FfISExNjY5NjM0MjE5LmpwZyIgYWxpZ249ImFic21pZGRsZSI+PGltZyBzcmM9Imh0dHBzOi8vaW1nLmFsaWNkbi5jb20vaW1nZXh0cmEvaTIvMTY2OTYzNDIxOS9PMUNOMDFxMGRYblAxaDJMYnhkbjNVUV8hITE2Njk2MzQyMTkuanBnIiBhbGlnbj0iYWJzbWlkZGxlIj48aW1nIHNyYz0iaHR0cHM6Ly9pbWcuYWxpY2RuLmNvbS9pbWdleHRyYS9pMi8xNjY5NjM0MjE5L08xQ04wMThrVndrdjFoMkxic2U0VXNFXyEhMTY2OTYzNDIxOS5qcGciIGFsaWduPSJhYnNtaWRkbGUiPjxpbWcgc3JjPSJodHRwczovL2ltZy5hbGljZG4uY29tL2ltZ2V4dHJhL2kxLzE2Njk2MzQyMTkvTzFDTjAxamRsN1VDMWgyTGJwRWRNUlVfISExNjY5NjM0MjE5LmpwZyIgYWxpZ249ImFic21pZGRsZSI+PGltZyBzcmM9Imh0dHBzOi8vaW1nLmFsaWNkbi5jb20vaW1nZXh0cmEvaTEvMTY2OTYzNDIxOS9PMUNOMDFNdmllSFUxaDJMYnRFb1J4Z18hITE2Njk2MzQyMTkuanBnIiBhbGlnbj0iYWJzbWlkZGxlIj48aW1nIHNyYz0iaHR0cHM6Ly9pbWcuYWxpY2RuLmNvbS9pbWdleHRyYS9pNC8xNjY5NjM0MjE5L08xQ04wMTMyQW5OTzFoMkxieGRtekxHXyEhMTY2OTYzNDIxOS5qcGciIGFsaWduPSJhYnNtaWRkbGUiPjwvcD48aW1nIGNsYXNzPSJkZXNjX2FuY2hvciIgaWQ9ImRlc2MtbW9kdWxlLTIiIHNyYz0iaHR0cHM6Ly9hc3NldHMuYWxpY2RuLmNvbS9raXNzeS8xLjAuMC9idWlsZC9pbWdsYXp5bG9hZC9zcGFjZWJhbGwuZ2lmIj48cD4gJmFtcDtuYnNwOzwvcD48cD4mYW1wO25ic3A7PGltZyBhbGlnbj0iYWJzTWlkZGxlIiBzcmM9Imh0dHBzOi8vaW1nLmFsaWNkbi5jb20vaW1nZXh0cmEvaTMvMTY2OTYzNDIxOS9UMk10bDBYREZYWFhYWFhYWFhfISExNjY5NjM0MjE5LmpwZyI+PGltZyBhbGlnbj0iYWJzTWlkZGxlIiBzcmM9Imh0dHBzOi8vaW1nLmFsaWNkbi5jb20vaW1nZXh0cmEvaTIvMTY2OTYzNDIxOS9UMmU5RlpYQnRYWFhYWFhYWFhfISExNjY5NjM0MjE5LmpwZyI+PGltZyBhbGlnbj0iYWJzTWlkZGxlIiBzcmM9Imh0dHBzOi8vaW1nLmFsaWNkbi5jb20vaW1nZXh0cmEvaTQvMTY2OTYzNDIxOS9UMjJ1bFpYcUphWFhYWFhYWFhfISExNjY5NjM0MjE5LmpwZyI+PGltZyBhbGlnbj0iYWJzTWlkZGxlIiBzcmM9Imh0dHBzOi8vaW1nLmFsaWNkbi5jb20vaW1nZXh0cmEvaTIvMTY2OTYzNDIxOS9UMlluUjJYclhYWFhYWFhYWFhfISExNjY5NjM0MjE5LmpwZyI+PC9wPjxwPjxpbWcgc3JjPSJodHRwczovL2ltZy5hbGljZG4uY29tL2ltZ2V4dHJhL2kxLzE2Njk2MzQyMTkvVEIyRHUwQmFYWFhYWFhLWHBYWFhYWFhYWFhYLTE2Njk2MzQyMTkuanBnIiBhbGlnbj0iYWJzbWlkZGxlIiBzdHlsZT0id2lkdGg6IDc5MC4wcHg7Ij48aW1nIHNyYz0iaHR0cHM6Ly9pbWcuYWxpY2RuLmNvbS9pbWdleHRyYS9pMS8xNjY5NjM0MjE5L1RCMmlMNEhhWFhYWFhiWlhYWFhYWFhYWFhYWC0xNjY5NjM0MjE5LmpwZyIgYWxpZ249ImFic21pZGRsZSIgc3R5bGU9IndpZHRoOiA3OTAuMHB4OyI+PGltZyBzcmM9Imh0dHBzOi8vaW1nLmFsaWNkbi5jb20vaW1nZXh0cmEvaTMvMTY2OTYzNDIxOS9UQjJxMzhCYVhYWFhYYTJYcFhYWFhYWFhYWFgtMTY2OTYzNDIxOS5qcGciIGFsaWduPSJhYnNtaWRkbGUiIHN0eWxlPSJ3aWR0aDogNzkwLjBweDsiPjwvcD48cD4mYW1wO25ic3A7PC9wPjxpbWcgY2xhc3M9ImRlc2NfYW5jaG9yIiBpZD0iZGVzYy1tb2R1bGUtMyIgc3JjPSJodHRwczovL2Fzc2V0cy5hbGljZG4uY29tL2tpc3N5LzEuMC4wL2J1aWxkL2ltZ2xhenlsb2FkL3NwYWNlYmFsbC5naWYiPjxwPjxpbWcgc3JjPSJodHRwczovL2ltZy5hbGljZG4uY29tL2ltZ2V4dHJhL2kzLzE2Njk2MzQyMTkvVEIyLjdKSWFYWFhYWGFwWFhYWFhYWFhYWFhYLTE2Njk2MzQyMTkuanBnIiBhbGlnbj0iYWJzbWlkZGxlIiBzdHlsZT0id2lkdGg6IDc5MC4wcHg7Ij48L3A+PGltZyBjbGFzcz0iZGVzY19hbmNob3IiIGlkPSJkZXNjLW1vZHVsZS00IiBzcmM9Imh0dHBzOi8vYXNzZXRzLmFsaWNkbi5jb20va2lzc3kvMS4wLjAvYnVpbGQvaW1nbGF6eWxvYWQvc3BhY2ViYWxsLmdpZiI+PHA+PGltZyBzcmM9Imh0dHBzOi8vaW1nLmFsaWNkbi5jb20vaW1nZXh0cmEvaTMvMTY2OTYzNDIxOS9PMUNOMDE2QVNBZUYxaDJMYmllZ3ExVF8hITE2Njk2MzQyMTkuanBnIiBhbGlnbj0iYWJzbWlkZGxlIiBzdHlsZT0id2lkdGg6IDcwMC4wcHg7Ij48L3A+PC9wPg==
Продавец:芘特菲母婴专营店
Адрес:Цзянсу
Рейтинг:

Всего отзывов:0
Положительных:0
Выберите вариацию / цвет
Выберите размер / комплектацию
- Смешанный, ароматный
Добавить в корзину
- Информация о товаре
- Фотографии
| Аромат: | Смешанный, ароматный |
| Цвет: | Антибактериальный сменный санитайзер для рук для одевания, 300 мл, 300 мл |

Обновление упаковки, в настоящее время новое и старое смешанное, на основе реального объекта